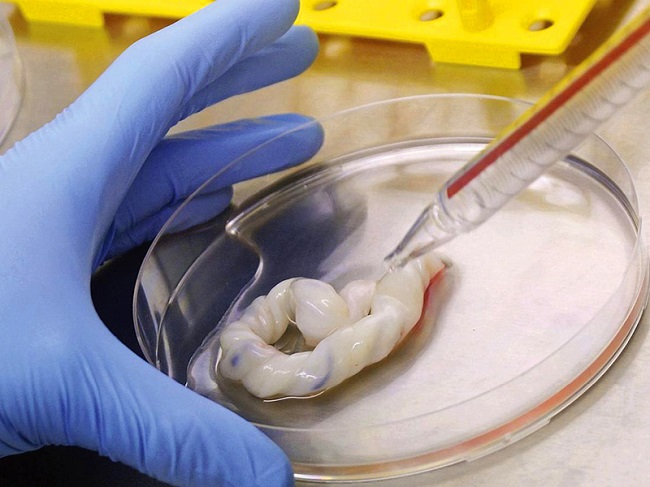
What alters proteins in eczema

9What alters proteins in eczema
Advertisement
The latest collaborative study between Newcastle University UK and GSK Stiefel identified molecular pathways and a series of proteins that was creating this dreaded problem. Lead research from Newcastle University Nick Reynolds said "We have shown for the first time that loss of the filaggrin protein alone is sufficient to alter key proteins and pathways involved in triggering eczema,"
The process to track down these proteins used a 3D lab created living skin model where the top layer of the skin was intentionally made to lack filaggrin similar to people who were afflicted with the mutation.
Image Source: adayroi.com
10Stress found to be one of the causes of eczema
Advertisement
The scientists then observed how filaggrin deficiency was responsible for changes in the molecular structure of various regulating mechanisms in the skin. These were mechanisms like the barrier function of a cell structure and how cells were affected by stress and got inflamed. It is widely considered that stress is one of the triggers of eczema. Thus stress combined with filaggrin deficiency was a sure shot risk of the condition. Inflammation because of ill-functioning skin barriers also triggered eczema.

Image Source: pinterest.com
1117 proteins linked to eczema problems
Advertisement
In the entire process, no less than 17 proteins were identified after removing filaggrin in ever LSE culture. The findings were then compared with an analysis of actual protein samples taken from the skin of humans with eczema and again a comparison between those results and the skin of healthy humans.
Among the identified proteins from skin samples of humans with eczema, only those afflicted with eczema were altered in the structure exactly in the same way as the demonstration from the LSE or lab model.

Image Source: epiphanytherapeutics.com
12A cure should be available soon with ongoing research
Advertisement
More research is necessary to pinpoint now the exact molecular pathways of the entire process in the absence of filaggrin and this will lead to a formulation of drugs that can prevent this happening. If that happens, then bye bye eczema. The biggest benefit and mammoth importance of such research is that it enables scientists to identify and treat the root causes of the disease rather than treat only the symptoms.

Image Source: britishmums.com